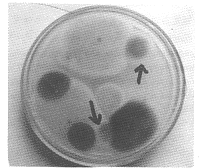

黄绿青霉素致大鼠心肌损伤的实验观察
作者:杨秋慧 王文阁 李群伟
单位:杨秋慧(中国地方病防治研究中心 大骨节病研究所,黑龙江 哈尔滨 150001)
关键词:黄绿青霉素;心肌;光镜观察
中国地方病学杂志000302 [摘要] 目的 观察黄绿青霉素(citreoviridin,CIT)对大鼠心肌的损伤。方法 用含CIT(每日每kg体重15mg)的染毒饲料喂养大鼠1个月,取心肌和肝脏组织,石蜡切片,光镜观察。结果 实验组大鼠心肌在左室壁内膜下、心尖、室中隔部位出现明显坏死等改变,病变呈灶状或条索状分布,涉及范围较大,有淋巴细胞和单核细胞浸润,心肌细胞呈颗粒变性,肌原纤维凝聚、崩解,部分肌纤维溶解。结论 CIT可致大鼠心肌原发性坏死,好发部位在左室内膜下,室中隔与心尖部位。
[中图分类号] Q954.56+1;Q954.66+3 [文献标识码] A
, 百拇医药
[文章编号]1000-4955(2000)03-0164-02
Experimental study on the myocardium damages in duced by CIT in rats
YANG Qiu-hui,WANG Wen-ge,LI Qun-wei
(Institute of KBD,Harbin Medical University,Harbin 150001,China)
[Abstract] Objective Observe the effects of CIT on the myocardium in rats with optical microscope.Methods The rats were fed with contaminated feed in the dose of CIT 15mg/kg body for one month,the heart and liver were taken away and embedded with parafine.We observed the sections with optical microscope.Results In the subendocardium of the left ventricle,apical part and interventricular septum,the pathologic changes of degeneration and necrosis were found out in some bigger size of point or rope type separately,in which the filtration of lymphocyte and mononuclear cells were seen in great quantities.The myocardial cells presented granular denaturation and myofibril lysis.Conclusions CIT caused original necrosis changes distributing mostly in the subendocardium of left ventricle,interventricular septum and apical tissue.
, 百拇医药
[Key words] CIT;Myocardium;Microscope
文献报告克山病患者多有食用霉捂粮食的历史,并提示病因物质与青霉菌污染有关[1]。另有文献报告青霉菌产物中有一种毒CIT,对心肌呈现特殊的毒作用[2]。作者曾报告CIT低剂量染毒试验可对大鼠心肌线粒体发生严重影响[3],本文报告用较高剂量CIT损伤大鼠心肌的进一步实验观察。
1 材料与方法
1.1 试剂仪器 主要试剂CIT为本实验室生产;Olympus光学显微镜。
1.2 实验动物与分组 Wister大鼠10只,体重50~60g,购自黑龙江省肿瘤医院实验动物中心。随机分两组,每组5只,对照组正常喂养,实验组按每kg体重15mg在饲料中投予CIT。
, 百拇医药
1.3 实验方法 大鼠喂养1个月后处死,取心肌和肝脏组织,用10%甲醛固定,常规石蜡包埋切片,采用苏木素-伊红染色,光镜观察。
2 结果
实验组大鼠心肌在左室壁或心尖、室中隔处均出现明显病变,病变呈灶状或条索状分布,涉及范围较大,有多量淋巴细胞和单核细胞浸润,心肌细胞呈颗粒变性,肌原纤维凝集、崩解,并有部分心肌纤维溶解性改变,且以心内膜下最重(图1,图2)。实验组大鼠肝脏汇管区有淋巴细胞聚集,但并无坏死发生。对照组无异常所见。
3 讨论
实验组大鼠心肌光镜观察结果表明,CIT可致大鼠心肌发生变性和坏死,呈灶状散在,涉及面较大,有淋巴细胞和单核细胞浸润,出现凝固样以及溶解样坏死,应属于吞噬阶段的较早病变,与本实验的亚急性特点符合,表明病变尚处于发展中。肝脏汇管区炎性细胞浸润应属中毒性改变。本实验观察的初步结论是:联系现场流行病学报告[1]以及相关文献资料[2],可以认为CIT是克山病的可疑致病因子。从病区粮食中分离黄绿青霉菌成功(图3),并在培养物中检出了大量CIT,是对本实验观察所见的一项重要支持。但从病因流行病学专业考虑,CIT作为病因物质,应该在活跃重病区粮食中存在超常聚积现象。目前,亟待解决的问题是确定病区粮食中该毒素分布状况,获得现场流行病学研究的支持与确认。
, 百拇医药
图1 低倍镜下可见实验组大鼠左室壁心内膜下病变呈灶状分布,涉及范围较大,有多量淋巴细胞和单核细胞浸润 33×
图2 高倍镜下心肌细胞呈颗粒变性,肌原纤维凝聚、崩解,并有部分心肌纤维溶解性改变 132×
图3 病区粮食中培养出的黄绿青霉菌(T5)
[基金来源]博士生课题费
[作者简介]杨秋慧(1972-),女,博士研究生
[参考文献]
[1] 杨建伯.克山病流行病学调查总结(1965~1975)—论发霉变质粮食的致病作用[A].第三届全国地方病学术会议论文集[C].中国地方病学杂志编辑部,1995,48-53.
, http://www.100md.com
[2] Ueno Y.Citreoviridin from penicillin citreo-viride biouge.Mycotoxins[M].Amsterdam-Oxford-New York,1974,291-300.
[3] 杨秋慧.黄绿青霉素对大鼠心脏线粒体影响的电镜观察[J].中国地方病学杂志,1999,18(5):321.
[4] 病理专题组.楚雄克山病科学考察病理学研究进展[A].楚雄克山病综合性科学考察文集(1984~1986)[C].人民卫生出版社,1988,138-142.
[收稿日期]1999-11-15
[修订日期]2000-01-26, http://www.100md.com
单位:杨秋慧(中国地方病防治研究中心 大骨节病研究所,黑龙江 哈尔滨 150001)
关键词:黄绿青霉素;心肌;光镜观察
中国地方病学杂志000302 [摘要] 目的 观察黄绿青霉素(citreoviridin,CIT)对大鼠心肌的损伤。方法 用含CIT(每日每kg体重15mg)的染毒饲料喂养大鼠1个月,取心肌和肝脏组织,石蜡切片,光镜观察。结果 实验组大鼠心肌在左室壁内膜下、心尖、室中隔部位出现明显坏死等改变,病变呈灶状或条索状分布,涉及范围较大,有淋巴细胞和单核细胞浸润,心肌细胞呈颗粒变性,肌原纤维凝聚、崩解,部分肌纤维溶解。结论 CIT可致大鼠心肌原发性坏死,好发部位在左室内膜下,室中隔与心尖部位。
[中图分类号] Q954.56+1;Q954.66+3 [文献标识码] A
, 百拇医药
[文章编号]1000-4955(2000)03-0164-02
Experimental study on the myocardium damages in duced by CIT in rats
YANG Qiu-hui,WANG Wen-ge,LI Qun-wei
(Institute of KBD,Harbin Medical University,Harbin 150001,China)
[Abstract] Objective Observe the effects of CIT on the myocardium in rats with optical microscope.Methods The rats were fed with contaminated feed in the dose of CIT 15mg/kg body for one month,the heart and liver were taken away and embedded with parafine.We observed the sections with optical microscope.Results In the subendocardium of the left ventricle,apical part and interventricular septum,the pathologic changes of degeneration and necrosis were found out in some bigger size of point or rope type separately,in which the filtration of lymphocyte and mononuclear cells were seen in great quantities.The myocardial cells presented granular denaturation and myofibril lysis.Conclusions CIT caused original necrosis changes distributing mostly in the subendocardium of left ventricle,interventricular septum and apical tissue.
, 百拇医药
[Key words] CIT;Myocardium;Microscope
文献报告克山病患者多有食用霉捂粮食的历史,并提示病因物质与青霉菌污染有关[1]。另有文献报告青霉菌产物中有一种毒CIT,对心肌呈现特殊的毒作用[2]。作者曾报告CIT低剂量染毒试验可对大鼠心肌线粒体发生严重影响[3],本文报告用较高剂量CIT损伤大鼠心肌的进一步实验观察。
1 材料与方法
1.1 试剂仪器 主要试剂CIT为本实验室生产;Olympus光学显微镜。
1.2 实验动物与分组 Wister大鼠10只,体重50~60g,购自黑龙江省肿瘤医院实验动物中心。随机分两组,每组5只,对照组正常喂养,实验组按每kg体重15mg在饲料中投予CIT。
, 百拇医药
1.3 实验方法 大鼠喂养1个月后处死,取心肌和肝脏组织,用10%甲醛固定,常规石蜡包埋切片,采用苏木素-伊红染色,光镜观察。
2 结果
实验组大鼠心肌在左室壁或心尖、室中隔处均出现明显病变,病变呈灶状或条索状分布,涉及范围较大,有多量淋巴细胞和单核细胞浸润,心肌细胞呈颗粒变性,肌原纤维凝集、崩解,并有部分心肌纤维溶解性改变,且以心内膜下最重(图1,图2)。实验组大鼠肝脏汇管区有淋巴细胞聚集,但并无坏死发生。对照组无异常所见。
3 讨论
实验组大鼠心肌光镜观察结果表明,CIT可致大鼠心肌发生变性和坏死,呈灶状散在,涉及面较大,有淋巴细胞和单核细胞浸润,出现凝固样以及溶解样坏死,应属于吞噬阶段的较早病变,与本实验的亚急性特点符合,表明病变尚处于发展中。肝脏汇管区炎性细胞浸润应属中毒性改变。本实验观察的初步结论是:联系现场流行病学报告[1]以及相关文献资料[2],可以认为CIT是克山病的可疑致病因子。从病区粮食中分离黄绿青霉菌成功(图3),并在培养物中检出了大量CIT,是对本实验观察所见的一项重要支持。但从病因流行病学专业考虑,CIT作为病因物质,应该在活跃重病区粮食中存在超常聚积现象。目前,亟待解决的问题是确定病区粮食中该毒素分布状况,获得现场流行病学研究的支持与确认。
, 百拇医药
图1 低倍镜下可见实验组大鼠左室壁心内膜下病变呈灶状分布,涉及范围较大,有多量淋巴细胞和单核细胞浸润 33×
图2 高倍镜下心肌细胞呈颗粒变性,肌原纤维凝聚、崩解,并有部分心肌纤维溶解性改变 132×
图3 病区粮食中培养出的黄绿青霉菌(T5)
[基金来源]博士生课题费
[作者简介]杨秋慧(1972-),女,博士研究生
[参考文献]
[1] 杨建伯.克山病流行病学调查总结(1965~1975)—论发霉变质粮食的致病作用[A].第三届全国地方病学术会议论文集[C].中国地方病学杂志编辑部,1995,48-53.
, http://www.100md.com
[2] Ueno Y.Citreoviridin from penicillin citreo-viride biouge.Mycotoxins[M].Amsterdam-Oxford-New York,1974,291-300.
[3] 杨秋慧.黄绿青霉素对大鼠心脏线粒体影响的电镜观察[J].中国地方病学杂志,1999,18(5):321.
[4] 病理专题组.楚雄克山病科学考察病理学研究进展[A].楚雄克山病综合性科学考察文集(1984~1986)[C].人民卫生出版社,1988,138-142.
[收稿日期]1999-11-15
[修订日期]2000-01-26, http://www.100md.com